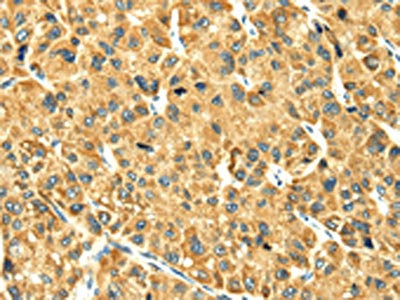

RAB2A Antibody
-
中文名稱:RAB2A兔多克隆抗體
-
貨號:CSB-PA226407
-
規(guī)格:¥1100
-
圖片:
-
The image on the left is immunohistochemistry of paraffin-embedded Human liver cancer tissue using CSB-PA226407(RAB2A Antibody) at dilution 1/25, on the right is treated with fusion protein. (Original magnification: ×200)
-
Gel: 12%SDS-PAGE,Lysate: 40 μg,Lane 1-4: K562 cells, Mouse brain tissue, 231 cells, HepG2 cells,Primary antibody: CSB-PA226407(RAB2A Antibody) at dilution 1/400 dilution,Secondary antibody: Goat anti rabbit IgG at 1/8000 dilution,Exposure time: 10 seconds
-
-
其他:
產(chǎn)品詳情
-
Uniprot No.:
-
基因名:
-
別名:9330148M11Rik antibody; C80220 antibody; GTP binding protein antibody; LHX antibody; OTTMUSP00000004796 antibody; RAB2 antibody; RAB2 member RAS oncogene family antibody; RAB2A antibody; RAB2A; member RAS oncogene family antibody; RAB2A_HUMAN antibody; Ras related protein Rab 2A antibody; RAS-associated protein RAB2 antibody; Ras-related protein Rab-2A antibody; RP23-183L6.1 antibody; Small GTP binding protein RAB2A antibody
-
宿主:Rabbit
-
反應(yīng)種屬:Human,Mouse,Rat
-
免疫原:Full length fusion protein
-
免疫原種屬:Homo sapiens (Human)
-
標(biāo)記方式:Non-conjugated
-
抗體亞型:IgG
-
純化方式:Antigen affinity purification
-
濃度:It differs from different batches. Please contact us to confirm it.
-
保存緩沖液:-20°C, pH7.4 PBS, 0.05% NaN3, 40% Glycerol
-
產(chǎn)品提供形式:Liquid
-
應(yīng)用范圍:ELISA,WB,IHC
-
推薦稀釋比:
Application Recommended Dilution ELISA 1:2000-1:5000 WB 1:500-1:2000 IHC 1:25-1:100 -
Protocols:
-
儲存條件:Upon receipt, store at -20°C or -80°C. Avoid repeated freeze.
-
貨期:Basically, we can dispatch the products out in 1-3 working days after receiving your orders. Delivery time maybe differs from different purchasing way or location, please kindly consult your local distributors for specific delivery time.
-
用途:For Research Use Only. Not for use in diagnostic or therapeutic procedures.
相關(guān)產(chǎn)品
靶點詳情
-
功能:Required for protein transport from the endoplasmic reticulum to the Golgi complex.
-
基因功能參考文獻:
- S100A7 affects cell motility and invasion by regulating the RAB2A-associated MAPK signaling cascades. PMID: 27767088
- Identify Rab2 as a key factor for autophagic and endocytic cargo delivery to and degradation in lysosomes. PMID: 28483915
- our data reveal that RAB2A is new critical membrane trafficking players in the regulation of mesenchymal properties of normal and tumorigenic cells and a critical determinant of an invasive, proteolytic mode of BC progression. PMID: 27255086
- RAB2A variance has effect on the structure and function of the PFC and related cognitive functions. PMID: 26249043
- This study demonstrated that RAB2A mutation showing the highest statistical significance in Autism and Schizophrenia. PMID: 26938441
- The immunohistochemistry-based validation using tissue microarray slides in oral squamous cell carcinoma revealed overexpression of the RAB2A and PRDX1 gene in 80 and 68 % of the tested clinical cases, respectively. PMID: 26159854
- Pin1/Rab2A/Erk drives BCSC expansion and tumorigenicity, suggesting potential drug targets. PMID: 25818297
- As a result of the translocations, RAB2A-PLAG1, the constitutively active promoter of the partner gene drives the ectopic expression of PLAG1. PMID: 24700772
- first X-ray crystal structure of RicA to 2.7 A resolution and have quantified the affinity of RicA binding to human Rab2 in its GDP-bound and nucleotide-free forms PMID: 24251537
- The authors identified a specific interaction between the human small GTPase Rab2 and a Brucella spp. protein named RicA. PMID: 21501366
- The results of this study provided that RAB2A and SLC38A1, were associated with the density of calbindin-positive neurons and the number of perineuronal oligodendrocytes in psychiatric disorders. PMID: 20308991
- Rab2 interacts directly with atypical protein kinase C iota/lambda and inhibits aPKCiota/lambda-dependent GADPH phosphorylation PMID: 14570876
- These data demonstrate that Rab2 and Rab6 differentially influence anterograde transport and signaling of GPCRs. PMID: 17716866
- ICA69 as a novel Rab2 effector and its role in regulating the early transport of insulin secretory granule proteins PMID: 18187231
顯示更多
收起更多
-
亞細(xì)胞定位:Endoplasmic reticulum-Golgi intermediate compartment membrane; Lipid-anchor. Melanosome. Endoplasmic reticulum membrane; Lipid-anchor. Golgi apparatus membrane; Lipid-anchor. Note=Identified by mass spectrometry in melanosome fractions from stage I to stage IV.
-
蛋白家族:Small GTPase superfamily, Rab family
-
數(shù)據(jù)庫鏈接:
Most popular with customers
-
-
YWHAB Recombinant Monoclonal Antibody
Applications: ELISA, WB, IHC, IF, FC
Species Reactivity: Human, Mouse, Rat
-
Phospho-YAP1 (S127) Recombinant Monoclonal Antibody
Applications: ELISA, WB, IHC
Species Reactivity: Human
-
-
-
-
-